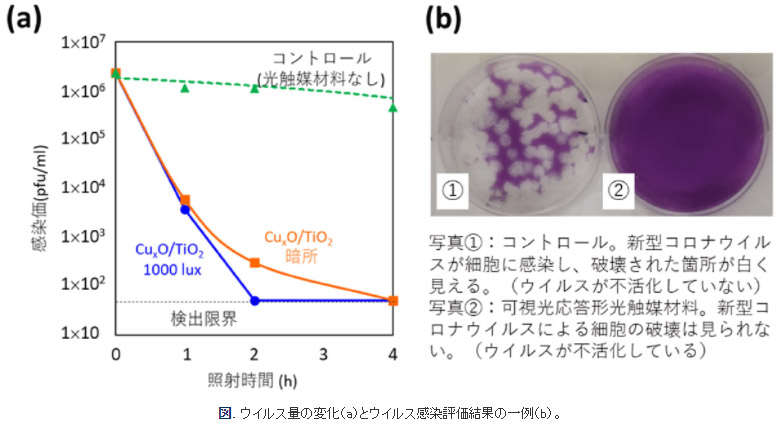
研究成果

取扱製剤Pharmaceutical Preparation
光触媒
光触媒の原理

従来の光触媒コーティング剤における問題点
- 基材へのアタック防止、コーティング対象物への接着のための「バインダー」が光触媒素材を隠蔽することで活性が大幅に弱められる。
- 紫外線による活性しかないので、室内では満足な活性が得られにくい。
- 防汚・消臭性能に関しては個人的主観に委ねられる部分が大きく、·抗菌・抗ウィルスについての有効性・実証性は根拠が乏しかった。


弊社使用光触媒のU.S.P
- 室内の可視光で非常に高い活性を発揮する
- 「抗菌・抗ウィルス性」の実証に成功した
- 業界初のバインダーレス光触媒コート剤

新型光触媒の検証結果


銅ドープ型他社製品との性能確認比較
| 目的 | 蛍光灯(可視光)とブラックライト(紫外線)照射によるトルエン分解性能試験 |
|---|---|
| 試験品 | 自動車車内消臭.抗菌用途用 弊社使用光触媒HF · L社銅担持品 |
| 対象品 | 綿布 |
| 試験方法 | ガスバッグ試験 S Lテドラーバッグ |
| 評価品 | トルエン |
| ガス充填塁 | 2L |
| 所見 | L社製品の効果は1年~2年とあり、銀イオン配合の光触媒製品と同様に可視光では性能が発揮しけれずに、銅や銀の抗菌作用に頼る面が大きい製品と確認できた。 |

新型光触媒ウイルス酸化分解性能
検証のとおり、ウイルスの不活性化は、ウイルス構成物質であるタンバク質や核酸の分解による不活性化であるため、変異が起こりやすい多種多様なウイルスに対し有効
・エボラウイルス・コロナウイルス・インフルエンザウイルス

エボラウイルス MERS(中東呼吸器症候群)コロナウイルスもインフルエンザウ イルスと同じよラにその遺伝子情報を持っRNたA(核酸)をタンバク質の膜で包んだものであり、光触媒により発生するOHラジカル(活性酸素)によりウイルスの不活性化が高いと考えます。

新型光触媒の検証結果



光触媒の役割
環境浄化材
光触媒は、医療部外品、消臭ー・抗菌材は雑貨の分類
※従来型(紫外線応答)光触媒で建物の防汚目的に使用された関係から「塗料」に分類され、監督官庁は国土交通省
※可視光応答型の開発により、材料として経済産業省製造産業局素材産業課が光触媒工業会を所管
JIS規格 ISO規格など制定に関しても同様
※(株)オペスは現在「光触媒工業会標準化委員会防藻部会委員」 で、JIS規格防藻性能試験法に関する経産省受託業務の部員
藻・徽の分解性能の評価基準

光触媒の機能
環境浄化材
- 空気浄化(大気:Nox 、Sox) / 大気の有害成分を太陽光によって分解
- 空気浄化(VOC 、臭い) / 室内等のvoe、臭い成分 を太陽光、室内光によって分解
- セルフクリーニング(建材) / 水によって汚れを流し、きれいな状態を保つ効果
- セルフクリ ーニング(ガラス PE · PC · PP) / 水によって汚れを流し、きれいな状態を保つ効果
- 防曇 / 光触媒の親水性を利用して防藝機能を発現→視認性が向上
- 水浄化 / 水中の有害物質を分解し、水を浄化する
- 抗菌性 / 光触媒の酸化分解性(活性酸素)を利用し、身の回りの雑菌を殺菌
- 抗ウイルス性 / 光触媒の酸化分解性(活性酸素)を利用し、各種ウイルスなどを不活化
- 抗カビ性 / 光郷楳の酸化分解性(活性酸素)を利用し、カビ胞子を不活化
- 防藻作用 / コンクリート壁、床や水槽の壁等微細藻類の繁殖を防ぐ
- 医療応用(歯の漂白) / 歯の汚れを光触媒により分解し、白い本来の色にする
- 医療応用(癌治療、感染予防) / 分解力を利用した癌細胞の不活化、医療器具の殺菌
- 光防食 / 金属が空気中で水、酸素による腐食(酸化)を防ぐ
- 印刷 / 親水性と疎水性のパターンを光触媒を利用し製作する。印刷版の再生が可能
- 有機合成 / 光触媒の酸化・還元を利用し、有機化合物を合成できる
- 水の分解(水素生成) / 水と太陽光から水素を合成
- 人口光合成 / 水と炭酸ガスと太陽光によって有機物を合成
エネルギー再生材
可視光応答形光触媒による新型コロナウイルス不活化を確認
概要
東京工業大学(物質理工学院 材料系 宮内雅浩教授)、奈良県立医科大学(微生物感染症学講座 中野竜一准教授)、神奈川県立産業技術総合研究所(研究開発部 抗菌・抗ウイルス研究グループ)の研究グループは世界で初めて可視光応答形光触媒材料(CuxO/TiO2)による新型コロナウイルスの不活化を確認しました。その不活化条件を実験的に明示することにより、光触媒による抗ウイルス効果を学問的に示しました。
背景
新型コロナウイルスの感染拡大防止として、様々な場所を使用した後には手作業によるアルコール拭き等が行われており、大変な労力と時間がかかっていました。この課題を解決する手段として、オゾンガスの利用などが実験的に明らかとなっています。しかし、これらは即効性があるものの持続的な抗ウイルス効果を保つ方法ではないため、持続性を持つ材料による新型コロナウイルスへの効果を学問的に確認する必要があります。
東京工業大学及び神奈川県立産業技術総合研究所は東京大学と共同で国立研究開発法人新エネルギー・産業技術総合開発機構(NEDO)の「循環社会構築型光触媒産業創成プロジェクト」(PL:橋本和仁教授(現NIMS理事長))において、非常に高い抗ウイルス効果を持つ可視光応答形光触媒材料[用語1]の開発に成功しています。この光触媒材料は酸化チタンと酸化銅からなり(CuxO/TiO2[用語2])、可視光照射下のみならず光のない状況においても、高い抗ウイルス効果を持つことをすでに報告しています[参考文献1-2]。今回の新型コロナウイルスによる評価結果でも、暗所ならびに日常空間で得られる光照射(1000 lux)でウイルスが不活化されることが判明し、感染拡大防止の一助となりうることが明らかとなりましたので報告します。
実験内容
可視光応答形光触媒による抗ウイルス性能評価試験として、JIS R 1756が制定されています。今回はその試験方法を参考にした試験を行いました。
新型コロナウイルス株を培養し、安全キャビネット内に設置した試験片(CuxO/TiO2粉体をガラスに担持)に対して、実験対象の新型コロナウイルスを接種します。その後、1000 luxの可視光照射(400 nm以下の紫外光をカットした白色蛍光灯を照射)を行いました。また、光触媒としての効果を確認するため、光の当たらない暗所条件での試験も行いました。一定時間経過後にウイルスを回収し、宿主細胞に接種、ウイルスが細胞に感染しているかを判定して、ウイルス量を算出しました。
研究成果
本光触媒材料に光照射をすることで、1時間で2.5桁のウイルス量の減少(99.7%の減少)、2時間で検出限界以下である99.99%以上のウイルス量が減少しました。また、暗所においても4時間で検出限界以下に減少させることを明らかにしました。このことから、本光触媒材料を利用することで、新型コロナウイルスを不活化できることがわかりました。本研究成果をもとに、学校、病院やその他多くの人が利用する公共施設等における飛沫の付着や人が触れる場所に対して、持続的な抗ウイルス効果を付与させることが可能になると考えられます。
用語説明
[用語1] 可視光応答形光触媒 : 可視光を吸収して表面に強い酸化力が生じ、接触するニオイ成分や有害物質などを酸化分解する物質。
[用語2] CuxO/TiO2 : 酸化銅と二酸化チタンの複合体で、CuxOのナノ粒子がTiO2の表面に担持されている。CuxOのxは、1<x<2の範囲をとり、銅の1価と2価の混合状態で存在する。
参考文献
[1] Masahiro Miyauchi, Kayano Sunada, Kazuhito Hashimoto, "Antiviral Effect of Visible Light-Sensitive CuxO/TiO2 Photocatalyst", Catalysts 10 (9), 1093, 2020. (DOI: 10.3390/catal10091093 outer )
[2] Masahiro Miyauchi, Hiroshi Irie, Min Liu, Xiaoqing Qiu, Huogen Yu, Kayano Sunada, Kazuhito Hashimoto, "Visible-light-sensitive Photocatalysts: Nanocluster-grafted Titanium Dioxide for Indoor Environmental Remediation", J. Phys. Chem. Lett. 7, 75-84, 2016. (DOI: 10.1021/acs.jpclett.5b02041 outer )
無光触媒
「光」不要な新触媒が誕生!
環境に優しく人体への安全性が証明されました。
無光触媒は、光触媒の弱点を克服したリン酸チタニウム系の新触媒です。分解時に光を必要とせず暗所でも効果を発揮し、無色透明でバインダー不要な為、そのまま何にでも塗布加工でき安全硬化後は非常に強固な多孔体組織を形成する為、剥離しにくく長年に渡り効果が持続します。有害な化学物質はもちろん暮らしの中のニオイのほとんどを吸着分解します。又、有害菌や細菌にも優れた抗菌・防カビ効果があることが証明されています。
特徴
効果
消臭効果
ニオイの分解・抑制を行う消臭効果
タバコのヤニ臭・ペット臭・汚物臭などのニオイを分解し、素材へのニオイの吸着を抑制します。また、近年問題とっなているシックハウス症候群の原因とされている有害化学物質なども分解・抑制します。
抗菌・防カピ効果
菌を分解し、発生・増殖を抑える抗菌・防カビ効果
食中毒の原因となる大腸菌・院内感染の問題となるMRSAなども分解し、菌の発生や増殖を抑えます。また、細菌が分解時に発生する毒素をも分解。優れた抗菌作用による防カビで衛生環境の維持に役立ちます。
防汚効果
汚れ難く、汚れても落ちやすい防汚効果
塗布面の静電気防止、セルフクリーニング効果によりタバコやヤニ・水アカ・油煙・排煙などの汚れを付き難くし、汚れたとしても落ちやすくなります。
ハイブリッド触媒
光触媒の弱点を克服する複合型光触媒
光触媒の強い酸化分解力!これを超える物質は地球上に存在しません。それでは、光触媒の弱点を克服するには、どの様にしたら良いのでしょう・・・
この問題を解決する為、当社では長年の研究の末、「複合型光触媒チタンテックス」を完成させます。光触媒を一つの浄化成分しとて考えて、無光触媒、白金、銀などのコロイド成分を複合し、光が無い環境でも実用的に利用できるようにしたのが、チタンテックスです。
複合型光触媒の構造図
チタンテックスでは、図のような原料を使用して製品が作られております。

性能試験の様子を御紹介

右の写真は、一般財団法人カケンテストセンターより頂いた、チタンテックスの性能評価試験の様子です。試験の方法を解説します。
- 10cm角の壁紙の片面にチタンテックスを塗布し、試験用のピニール袋(ガスバッグ)に投入して外気を遮断します。
- この袋へ濃度管理された臭い成分を3L注入します。右の写真。
- 当社では、ホルムアルデヒドとアンモニアを使用して試験依頼しました。
※初期濃度は、ホルムアルデヒド40ppm、アンモニア100ppm指定。 - 500Luxの蛍光灯を照射して、1時間後、6時閻後の臭いの変化を計測します。
Point1/ 袋の中の小さな光触媒片が、空間の臭いをどの程度分解するか?
Point2/ 臭いの濃度は、人体に悪影響を及ぽす高濃度ガスを指定した。
※試験データは下記に記載。
カビ研究の最先端をゆく東京都産業技術センターさん

右の写真は、東京都産業技術センターの試験室です。
当社では、カビの成長を抑制する力を当試験室で実施して頂きます。
試験の方法は・・・
- シャーレの底にチタンテックスを塗布した試験片を岡きます。
- 試験片に5種類のカビの胞子(卵)を塗ります。
- 25~28 ℃の室温、95%の湿度に管理した恒温室に28日間入れカビを培養。
Point1/ カビの胞子が成長して試験片に菌糸が発生したら、不合格。
Point2/ 光が無い環境下で行う当試験は、一般の光触媒製品は行わない。
各種試験データ/ 第三者試験




安全性試験
試験方法及び試験結果は以下のとおりです。報告書より抜粋。
急性経口毒性試験
試験結果/ 毒性無し
試験実施機関 / 一般財団法人 日本食品分析センター
試験番号/ 第 15133220001-0101号
試験実施日 / 平成28年 1月20日
試験表題/ 雄ラットを用いる急性経口毒性試験
試験方法及び評価
チタンテックスを検体として、雄ラットを用いる急性経口毒性試験(限度試験)を実施した。
2000mg/kgの用量の検体を雄ラットに単回経口投与し、14日間観察を行なった。
その結果、観察期間中に異常及び死亡例は認められなかった。以上のことより、ラットを用いた単回経口投与において、検本のLD値は雄では2000mg/kgを超えるため「毒性無し」範疇に入るものと評価する。
皮膚一次刺激性試験
試験結果/ 無刺激性
試験実施機関/一般財団法人 日本食品分祈センター
試験番号/ 第 16038206001-0101号
試験実施日 / 平成28年 5月19日
試験表題/ ウサギを用いる皮膚一次刺激性試験
試験方法と評価
チタンテックスを検体として、OECD Guideline for Testing of Chemicals 404 (2015)に準拠し 、ウサギを用いる皮膚一次刺激性試験を実施する。検体をウサギ3匹の無傷及び有傷皮膚に4時間鎖適適応した。その結果、除去後1時間に全例で紅斑が見られたが、
48時間までに消失した。ISO 10993-10 Biological evaulation of medical devices-part 10 (2010) に従って求めた一次刺激性インデックス (P ·I· I) は0.2となる。
以上のことより、ウサギを用いる皮膚一次刺激性試験において、検体は「無刺激性」範疇に入るものと評価する。
「急性経口毒性試験」及び「皮膚一次刺激性試験」試験は、チタンテックス原液における安全性を評価するもの。施工完成部に人が触れても人体に影響は有りません。
本書は、試験機関通達により報告書原本のコピー及び複製が禁止されている為、報告書記載内容を元に正確に作成したものです。
